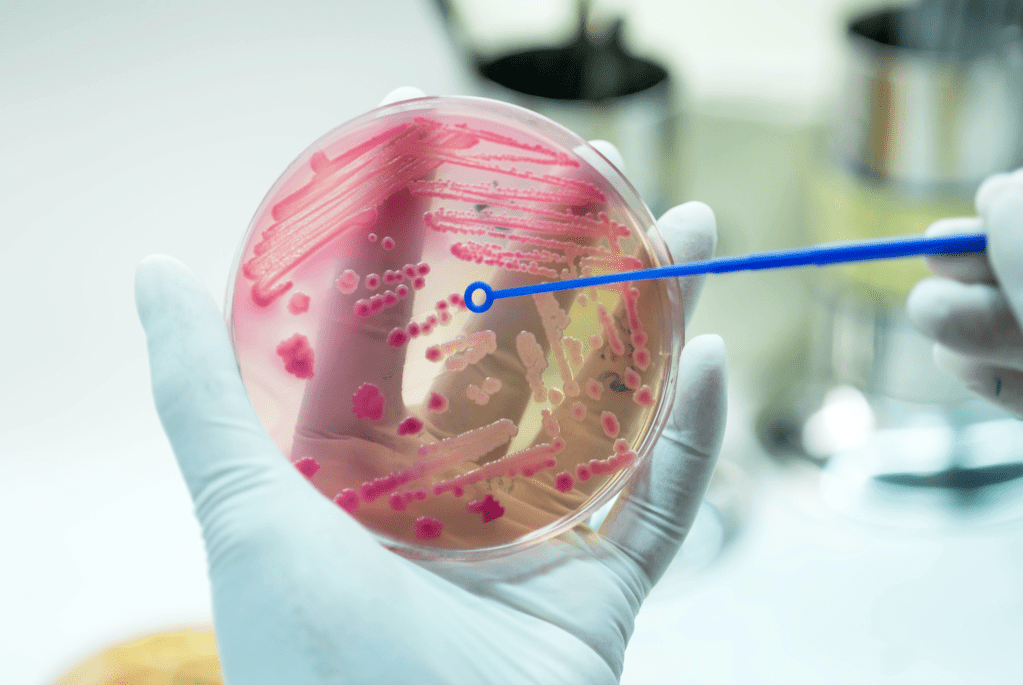

Renlighet genom kunskap, och golvvård genom innovation. Sveing AB är i framkant med effektiva arbetsmetoder inom lokalvård, och tekniska lösningar för hållbara och estetiskt vackra golv.


Djuprengöring och mattvätt men med en unik allergen-nedbrytande lösning

Yrkesmässig fönsterputsning, men även specialistkunskaper inom höghöjdsarbeten

Dammfri golvslipning med exempelvis hårdvaxolja som yta är miljövänligt och tidlöst
ATP-mätningar enligt Nordisk standard för städkvalitet; INSTA-800

Återställning av stengolv genom preparerade rondeller innehållande mikroskopiska diamanter

Certifierade städning med miljömärkta produkter eller avjoniserat vatten
100 %
Eldrivna bilar och maskiner (2023)
3 %
Personalomsättning (2023)
99,4%
Total kundretention (2023)


info@sveing.se